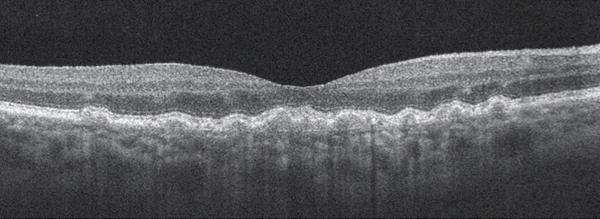

Spotting AMD in the OD’s Office
Primary eye care providers have room to improve when it comes to identifying patients with age-related macular degeneration (AMD). A study published in JAMA Ophthalmology found that nearly 25% of eyes that underwent dilated eye examination by a primary eye care optometrist or ophthalmologist and were determined to be normal actually showed signs of AMD on fundus photography; of those eyes with signs of AMD that went undiagnosed, 30% had large drusen.1
Optometrists are the gatekeepers of sight. They are often the first to detect when a patient’s symptoms require referral to a retina subspecialist or comprehensive ophthalmologist. Treatment options for AMD continue to improve, allowing earlier intervention before vision is lost. It is incumbent upon optometrists to make sure that they identify symptoms of the disease so that patients can receive treatment in a timely manner.
GETTING TO KNOW YOUR DRUSEN
Before any imaging is employed, it is key to view the fundus via slit-lamp biomicroscopy and determine the presence and degree of macular pigment changes and the approximate size and number of drusen. Small drusen (<63 µm) are consistent with normal aging processes and present little increased risk of late AMD developing. Medium-sized drusen (63-125 µm) are more likely to progress to early AMD and signal an increased risk of developing late AMD; the presence of abnormalities in the retinal pigment epithelium (RPE) increases that risk (Figure 1).2
Figure 1. Dry AMD with disruption to the RPE layer with no evidence of subretinal fluid or choroidal neovascular membrane.
Large drusen (>125 µm) are associated with a much higher risk for developing advanced AMD. (For perspective, the diameter of the central retinal vein as it leaves the optic nerve head is 125 µm; Figure 2.) Patients with large drusen are five times more likely to develop AMD within a 5-year period than those who have no evidence of drusen.3

Figure 2. Dry AMD with multiple large drusen.
IMAGING
Optometrists commonly encounter AMD during comprehensive dilated eye examinations. When early signs of age-related changes are noted, optometrists may use a variety of retinal imaging platforms to assess the stage of the macular degeneration and to monitor for progression. Digital fundus photography, fundus autofluorescence (FAF), optical coherence tomography (OCT), and OCT angiography (OCTA) are some of the most commonly employed imaging technologies.
Fundus Photography
Fundus photos are important for documenting the appearance of the macula and an excellent tool for patient education. They can be particularly useful when seeking to demonstrate progressive changes that have occurred in the retina over time.
FAF
FAF, an imaging technique facilitated by the autofluorescence of lipofuscin in the RPE, can be used to identify early changes in the RPE. Areas that are hyperautofluorescent on FAF indicate areas of the RPE that are accumulating lipofuscin, a sign of metabolic stress and RPE dysfunction. Areas that are hypoautofluorescent on FAF represent areas of photoreceptor loss or retinal cell atrophy, damage that typically occurs in later stages of the disease process.4
OCT and OCTA
To monitor for the conversion of nonexudative to exudative AMD, OCT is of particular value as it allows the retina to be examined in cross-section. This enables the optometrist to confirm or rule out the presence of subretinal fluid secondary to choroidal neovascularization (CNV).
OCTA is a relatively new technology for imaging the retina and the retinal and choroidal vasculature. Currently, the »Cirrus 5000 Angioplex (Carl Zeiss Meditec) and the »AngioVue (Optovue) offer OCTA; similar platforms from Topcon and Heidelberg Engineering will soon be available in the United States. CNV can be detected directly with OCTA, giving clinicians a chance for early diagnosis of exudative AMD (Figure 3).5

Figure 3. OCTA of a patient with AMD. The yellow arrows indicate evidence of choroidal neovascular membrane.
RISK FACTORS
The optometrist’s role is not only to diagnose AMD when clinical signs are present, but also to identify patients with a predisposition for developing AMD. This is accomplished by identifying known risk factors for AMD through taking detailed medical, social, and family histories of each patient.
Macular pigment optical density (MPOD) testing is a noninvasive, in-office screening test to help identify patients who have known risk factors for AMD. MPOD reflects the levels of carotenoids present in the macula. If a low MPOD is found, nutritional supplementation may be recommended to help increase MPOD and potentially reduce the risk of developing AMD.6,7
PROMPT REFERRAL AND TREATMENT
Optometrists have access to various methods of detecting early age-related macular changes, monitoring for progression or conversion from nonexudative to exudative disease, and assessing a patient’s risk factors for developing AMD. Through the use of these advanced technologies, optometrists can better explain to patients their risk of developing AMD and educate them on lifestyle or dietary modifications that may help to lower their risk. Patients can then be confident that, once a diagnosis of AMD is made, their optometrist will continue to monitor them closely and refer promptly for treatment if the need arises.
- Neely DC, Bray KJ, Huisingh CE. Prevalence of undiagnosed age-related macular degeneration in primary eye care. JAMA Ophthalmol. 2017;135(6):570-575.
- Joachim ND, Mitchell P, Kifley A, Wang JJ. Incidence, progression, and associated risk factors of medium drusen in age-related macular degeneration: findings from the 15-year follow-up of an Australian cohort. JAMA Ophthalmol. 2015;133(6):698-705.
- Wang JJ, Foran S, Smith W, et al. Risk of age-related macular degeneration in eyes with macular drusen or hyperpigmentation: The Blue Mountains Eye Study cohort. Arch Ophthalmol. 2003;121(5):658-663.
- Ly A, Nivison-Smith L, Assaad N, et al. Fundus autofluorescence in age-related macular degeneration. Optom Vis Sci. 2017;94(2):246-259.
- De Carlo TE, Romano A, Waheed NK, et al. A review of optical coherence tomography angiography. Int J Retina Vitreous. 2015;1: 5.
- Mellerio J, Ahmadi-Lari S, van Kuijk F, et al. A portable instrument for measuring macular pigment with central fixation. Curr Eye Res. 2002;25(1):37-47.
- Bone RA, Landrum JT, Cao Y, et al. Macular pigment response to a supplement containing meso-zeaxanthin, lutein and zeaxanthin. Nutr Metab (Lond). 2007;4:12.
Ready to Claim Your Credits?
You have attempts to pass this post-test. Take your time and review carefully before submitting.
Good luck!





